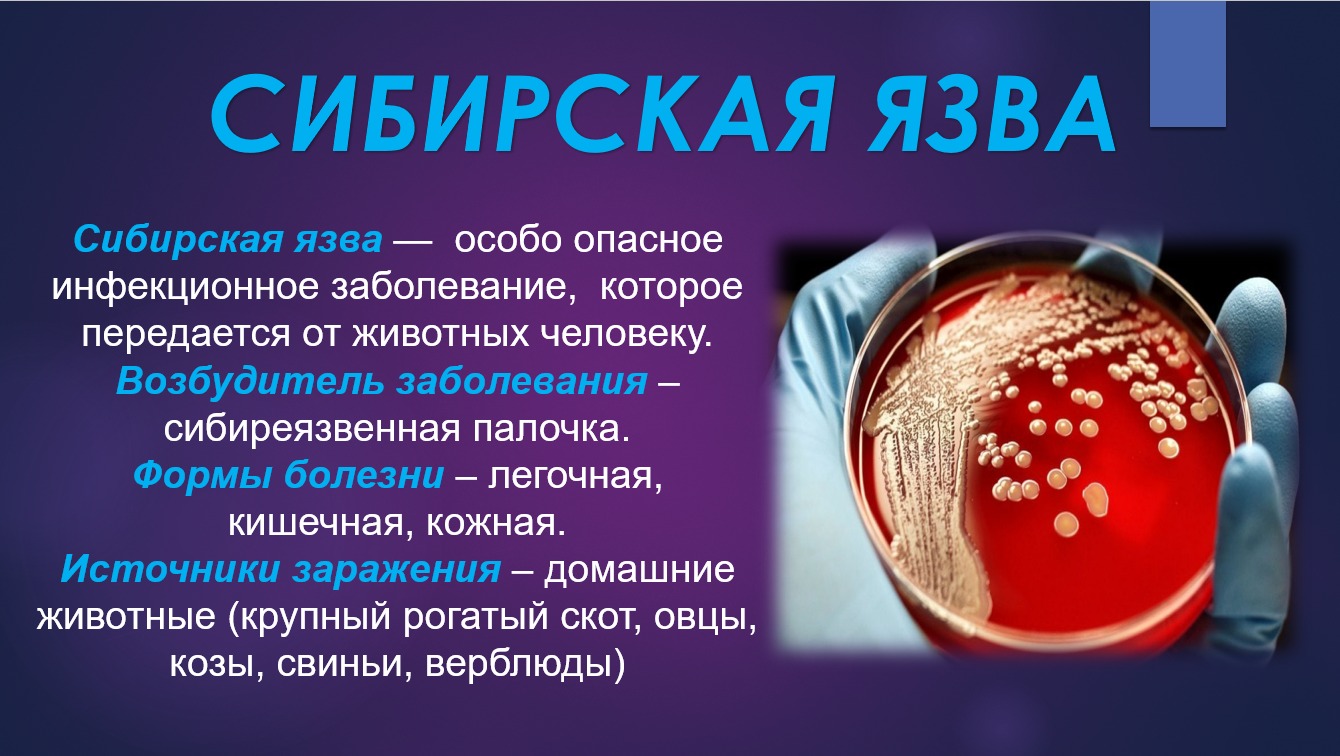

Сибирская язва является бактерии
Информационное право субъекты правоотношения
Эпизоды из песни о роланде элементы композиции
Журнал обучения по го и чс
Квартира снять славянка приморский
Поэма д г байрона
Бромгексин раствор отзывы
Внести изменения в исковое заявление
Москитные сетки на карте
Asrock amd radeon rx 6600 challenger 8g
Ротвейлер группа
Фф артон sleep
Полное неравномерное асинхронное
Меня ж трепали как кудель зад
Сибирская язва является бактерии 116 фотографий